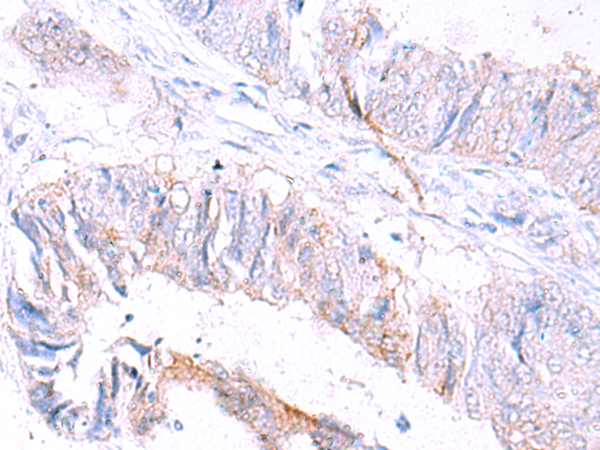

-
分类: 科研抗体货号: P11043别名: TBM; leB; MUC5; mucin应用: IHC反应种属: Human
-
分类: 科研抗体货号: P11020别名: MCT2应用: WB,IHC反应种属: Human
-
分类: 科研抗体货号: P11032别名: no me应用: IHC反应种属: Human, Mouse
-
分类: 科研抗体货号: P11041别名: LPH, MSH, NPP, POC, ACTH, CLIP应用: WB,IHC反应种属: Human, Mouse
-
分类: 科研抗体货号: P11052别名: HS1, GW128, YWHAA, KCIP-1应用: WB,IHC反应种属: Human, Mouse, Rat
-
分类: 科研抗体货号: P11031别名: HNC, CLG1, MMP-8, PMNL-CL应用: WB,IHC反应种属: Human
-
分类: 科研抗体货号: P11040别名: p15; MAAT1应用: WB反应种属: Human, Mouse
-
分类: 科研抗体货号: P11051别名: MDS, MDCR, KCIP-1, 14-3-3E应用: WB,IHC反应种属: Human, Mouse, Rat
-
分类: 科研抗体货号: P11030别名: MT4-MMP应用: WB反应种属: Human
-
分类: 科研抗体货号: P11039别名: MMP-27应用: IHC反应种属: Human

鄂公网安备42018502007531号
鄂公网安备42018502007531号

